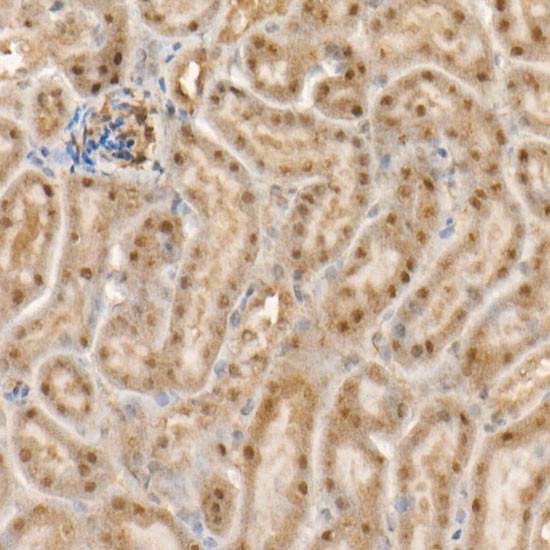
c-Abl Antibody in Immunohistochemistry (Paraffin) (IHC (P))

Search
Invitrogen
c-Abl Recombinant Rabbit Monoclonal Antibody (4Y8V9)
{{$productOrderCtrl.translations['antibody.pdp.commerceCard.promotion.promotions']}}
{{$productOrderCtrl.translations['antibody.pdp.commerceCard.promotion.viewpromo']}}
{{$productOrderCtrl.translations['antibody.pdp.commerceCard.promotion.promocode']}}: {{promo.promoCode}} {{promo.promoTitle}} {{promo.promoDescription}}. {{$productOrderCtrl.translations['antibody.pdp.commerceCard.promotion.learnmore']}}
图: 1 / 2
c-Abl Antibody (MA5-51220) in IHC (P)


产品信息
MA5-51220
种属反应
宿主/亚型
Expression System
分类
类型
克隆号
抗原
偶联物
形式
浓度
规格
纯化类型
保存液
内含物
保存条件
运输条件
RRID
产品详细信息
Immunogen sequence: TAFIPLISTR VSLRKTRQPP ERIASGAITK GVVLDSTEAL CLAISRNSEQ MASHSAVLEA GKNLYTFCVS YVDSIQQMRN KFAFREAINK LENNLRELQI CPATAGSGPA ATQDFSKLLS SVKEISDIVQ R
靶标信息
The ABL1 proto-oncogene encodes a cytoplasmic and nuclear protein tyrosine kinase that has been implicated in processes of cell differentiation, cell division, cell adhesion, and stress response. Activity of c-Abl protein is negatively regulated by its SH3 domain, and deletion of the SH3 domain turns c-Abl into an oncogene. The DNA-binding activity of the ubiquitously expressed ABL1 tyrosine kinase is regulated by CDC2-mediated phosphorylation, suggesting a cell cycle function for c-Abl. In chronic myelogenous leukemia and a subset of acute lymphoblastic leukemias, the c-Abl proto oncogene undergoes a (9;22) chromosomal translocation producing a novel rearranged chromosome (the Philadelphia chromosome). As the result of the fusion of c-Abl sequences from chromosome 9 to the Bcr gene on chromosome 22. The c-Abl oncogene was initially identified as the viral transforming gene of Abelson murine leukemia virus (A-MuLV). c-ABL potentially regulates DNA repair by activating the proapoptotic pathway when the DNA damage is too severe to be repaired.
仅用于科研。不用于诊断过程。未经明确授权不得转售。
篇参考文献 (0)
生物信息学
蛋白别名: Abelson murine leukemia oncogene; Abelson murine leukemia viral (v-abl) oncogene homolog 1; Abelson murine leukemia viral oncogene homolog 1; Abelson tyrosine-protein kinase 1; Abl 1 antib; ABL2; ABLL; ARG; B30; c-abl oncogene 1, non-receptor tyrosine kinase; c-abl oncogene 1, receptor tyrosine kinase; p150; Proto-oncogene c-Abl; proto-oncogene tyrosine-protein kinase ABL1; RP11-83J21.1; Tyrosine kinase ARG; Tyrosine-protein kinase ABL1; v-abl Abelson murine leukemia oncogene 1; v-abl Abelson murine leukemia viral oncogene 1
基因别名: Abl; Abl1; AI325092; c-Abl; E430008G22Rik
UniProt ID: (Mouse) P00520
Entrez Gene ID: (Rat) 311860, (Mouse) 11350